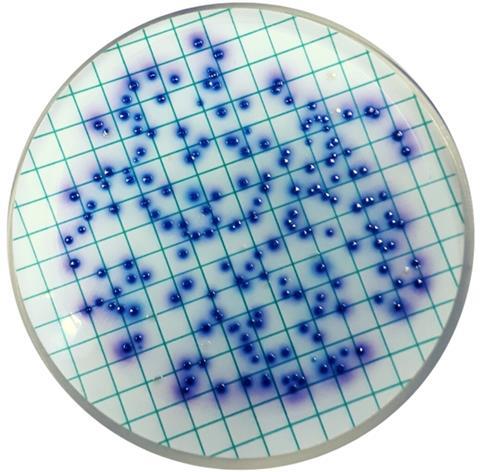

This breakthrough enables higher yields of poly(3-hydroxybutyrate-co-lactate) [P(3HB-co-LA)] without disrupting bacterial growth, paving the way for more sustainable bioplastic manufacturing.
The mounting global challenge of plastic waste, often referred to as “white pollution,” underscores the urgent need for eco-friendly alternatives. Biobased degradable plastics, such as polyhydroxyalkanoates (PHAs), offer a sustainable path forward because of their reduced carbon footprint and natural degradation.
READ MORE: Revolutionizing bioplastics: a microbial platform for fully bio-based long-chain polyesters
READ MORE: Researchers use microbes to create biodegradable bioplastics from food waste
Among these, P(3HB-co-LA) has drawn attention for its tunable thermal and mechanical properties, determined by the lactate fraction (LAF) incorporated into the polymer. However, traditional methods to increase LAF—such as enzyme modification or overexpression of lactate pathways—have often led to metabolic imbalances, byproduct accumulation, and growth inhibition.
A study (DOI:10.1016/j.bidere.2025.100027) published in BioDesign Research on 6 June 2025 by Hui Wu’s team, East China University of Science and Technology, represents a flexible and scalable method for producing next-generation bioplastics.
Coenzyme engineering
Using coenzyme engineering, the study first implemented a phosphite dehydrogenase (PtxD)-based NADH regeneration module to decouple cofactor supply from central carbon metabolism and drive lactate formation for P(3HB-co-LA) copolymer synthesis in E. coli. The ptxD gene was expressed from pBAD33-Ptrc in strain WJPCT-02P and tested in shake flasks with 10 g/L glucose or xylose, 20 mM phosphite, and IPTG at 0.05/0.10/0.15 mM to tune expression.
To probe carbon-source dependence, the team next enhanced the lactate pathway and blocked competing routes (deleting pyruvate-to-acetate and formate branches and replacing the native ldhA promoter with constitutive m2) to build WJLA-02P, then repeated the IPTG gradient on glucose.
Finally, to improve stability and reduce burden, ptxD was integrated into the chromosome (yeep locus) to create WJPCTP, yielding production strain WJPCTP-01 (harboring pTrc99aABC). Intracellular NADH was quantified, ptxD transcripts compared by RT-qPCR, copolymer molecular weights measured, and the best design scaled in a 5 L bioreactor on xylose.
Improved performance
Correspondingly, with plasmid-borne ptxD, glucose runs showed low LAFs (3.8–4.2 mol%) and only 0.07 g/L lactate, whereas xylose increased LAF to 6.2–10.0 mol% and lactate to 0.19 g/L, with minor growth/uptake penalties—consistent with carbon-source-specific redox and acetylation effects.
Carbon yield improved, likely via partial TCA downshift and transhydrogenase-mediated boosting of NADPH for 3HB-CoA supply. On the pathway-strengthened chassis (WJLA-02P, glucose), lactate rose to 4.3 g/L, acetate peaked at 0.4 g/L, and LAF reached 12.7–16.7 mol%.
Strikingly, genome integration further elevated performance: WJPCTP-01 achieved LAFs of 23.0 mol% (glucose) and 39.0 mol% (xylose) and higher intracellular NADH despite lower ptxD transcript levels than the plasmid strain, underscoring genomic stability advantages.
Molecular-weight analysis revealed a maximum of 324,000 Da at 23.0 mol% LA (and 142,000 Da at 39.0 mol%). In 5 L runs on xylose, LAF increased from 27.9 mol% (24 h) to 41.3 mol% final, yielding 8.57 g/L at 0.12 g/L·h with only 1.58 g/L acetate—outperforming prior ldhA overexpression strategies prone to high residual lactate and acetate.
In summary, the PtxD-based NADH regeneration platform enables flexible, efficient, and scalable biosynthesis of lactate-based copolymers. With further optimization, this strategy could unlock commercial-scale production of environmentally friendly plastics and contribute to global efforts to mitigate plastic pollution.
No comments yet